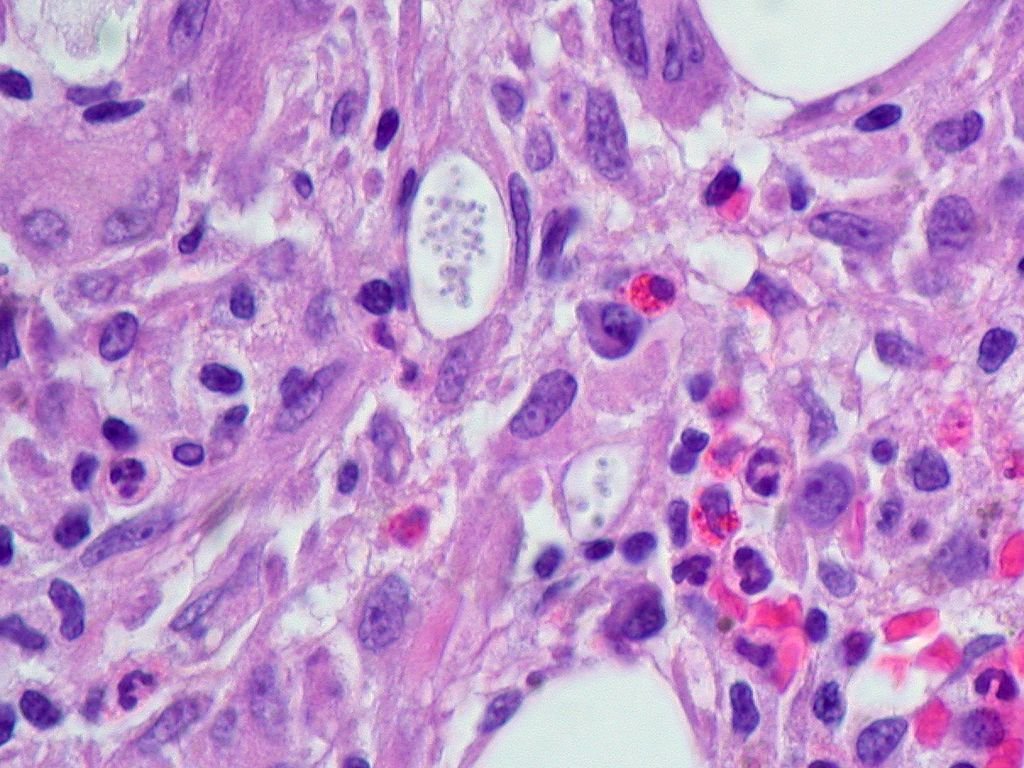

Fungal infections are a common health concern that can affect various parts of the body, including the skin, nails, and internal organs. Ayurveda, an ancient system of medicine, offers natural and holistic approaches to treating fungal infections. By understanding the principles of Ayurveda and incorporating herbal remedies, dietary adjustments, and lifestyle changes, individuals can effectively manage and prevent fungal infections. In this article, we will explore the Ayurvedic way of naturally treating fungal infections and discuss key takeaways for a holistic approach to wellness.
Key Takeaways
- Ayurveda emphasizes the balance of bodily energies (doshas) to promote overall health and well-being.
- Herbal remedies such as neem, turmeric, and aloe vera have antifungal properties and can be used to treat fungal infections.
- Dietary adjustments, including consuming anti-fungal foods like garlic and coconut oil, can support the body’s natural defense against fungal infections.
- Maintaining proper hygiene, avoiding damp environments, and wearing breathable clothing can help prevent fungal infections.
- Integrating Ayurvedic treatments with modern medicine can provide comprehensive care for fungal infections and promote long-term wellness.
Understanding Fungal Infections
What are Fungal Infections?
Fungal infections are caused by fungi that invade the body, leading to various symptoms such as itching, redness, and swelling. These infections can affect the skin, nails, and internal organs. It is important to understand the different types of fungal infections and their causes. Below is a table outlining the common types of fungal infections:
| Type of Infection | Description |
|---|---|
| Dermatophytes | Affect the skin, hair, and nails |
| Candida | Affects the mouth, throat, and genitals |
| Aspergillus | Affects the lungs and respiratory system |
- Proper diagnosis is crucial for effective treatment.
Early detection and treatment are essential for preventing complications.
Common Types of Fungal Infections
In addition to the well-known types of fungal infections such as athlete’s foot and ringworm, there are several other common fungal infections that can affect the skin, nails, and mucous membranes. These include candidiasis, tinea versicolor, and onychomycosis. Recognizing the symptoms of these infections is crucial for prompt treatment. Below is a table outlining the common types of fungal infections:
| Type of Infection | Symptoms | Treatment |
|---|---|---|
| Athlete’s Foot | Itchy, red, peeling skin | Antifungal cream |
| Ringworm | Red, scaly, itchy patches | Antifungal medication |
| Candidiasis | White patches in mouth or throat | Antifungal lozenges |
| Tinea Versicolor | Light or dark patches on skin | Antifungal shampoo |
| Onychomycosis | Thickened, discolored nails | Oral antifungal medication |
It is important to seek medical advice if you suspect a fungal infection, especially if the symptoms persist or worsen.
Causes of Fungal Infections
Fungal infections can occur due to a variety of factors, including weakened immune system, poor hygiene, and environmental exposure. The table below lists some common causes of fungal infections:
| Common Causes |
|---|
| Weakened immune system |
| Poor hygiene |
| Environmental exposure |
- It is important to note that certain medical conditions and medications can also contribute to the development of fungal infections.
Understanding the underlying causes of fungal infections is crucial in developing effective treatment and preventive strategies.
Ayurvedic Approach to Treating Fungal Infections
Principles of Ayurveda
In the Ayurvedic approach to treating fungal infections, the Principles of Ayurveda play a crucial role. These principles emphasize the balance of the body’s energies, or doshas, to promote overall health and well-being. According to Ayurveda, the treatment of fungal infections involves addressing the underlying imbalances in the body. This approach utilizes a combination of herbal remedies, dietary adjustments, and lifestyle modifications to restore harmony and support the body’s natural defense mechanisms. The table below provides a list of common herbs used in Ayurveda for treating fungal infections:
| Herb Name | Properties |
|---|---|
| Neem | Antifungal, antibacterial, and antiviral |
| Turmeric | Anti-inflammatory and antimicrobial |
| Amla | Rich in vitamin C and immune-boosting |
Additionally, Ayurveda advocates for maintaining a healthy immune system and recommends specific dietary practices and lifestyle habits to strengthen the body’s natural defenses. This holistic approach aims to not only address the symptoms of fungal infections but also to prevent their recurrence. By integrating these principles into daily life, individuals can support their overall well-being and resilience against fungal infections.
Herbal Remedies for Fungal Infections
In the Ayurvedic approach to treating fungal infections, herbal remedies play a significant role. These remedies are derived from natural plant sources and are known for their antifungal properties. Neem, Turmeric, and Tulsi are some of the commonly used herbs. The effectiveness of these remedies is supported by centuries of traditional use and modern research. The table below provides a list of commonly used herbs and their antifungal properties.
| Herb | Antifungal Properties |
|---|---|
| Neem | Antimicrobial, Antifungal |
| Turmeric | Antimicrobial, Antifungal |
| Tulsi | Antimicrobial, Antifungal |
The use of herbal remedies in Ayurveda is based on the holistic approach to healing, which emphasizes the balance of mind, body, and spirit. It is important to consult a qualified Ayurvedic practitioner before using these remedies. The wisdom of Ayurveda emphasizes the personalized approach to treatment, taking into account an individual’s unique constitution and imbalances.
Ayurveda teaches us to harness the healing power of nature and to respect the interconnectedness of all living beings.
Dietary and Lifestyle Recommendations
In addition to herbal remedies, adopting a balanced diet and making positive lifestyle changes can greatly aid in the treatment of fungal infections. A diet rich in antioxidant-rich foods such as berries, green leafy vegetables, and nuts can help boost the body’s immune system. Additionally, incorporating regular exercise and stress-reducing activities can contribute to overall well-being and immune function. It is important to consult with a qualified Ayurvedic practitioner to develop a personalized dietary and lifestyle plan.
It is essential to remember that consistency in following these recommendations is key to achieving long-term relief from fungal infections.
| Dietary and Lifestyle Recommendations |
|---|
| – Balanced Diet |
| – Antioxidant-rich Foods |
| – Regular Exercise |
| – Stress-reducing Activities |
Preventive Measures for Fungal Infections
Hygiene Practices
Maintaining good hygiene is crucial in preventing and managing fungal infections. Regular handwashing, keeping skin dry, and wearing clean, breathable clothing are essential practices. Additionally, environmental cleanliness plays a significant role in reducing the risk of fungal infections. Implementing proper hygiene practices can greatly contribute to overall health and well-being.
It is important to remember that prevention is key in avoiding fungal infections. By following these hygiene practices, individuals can create a healthier environment for themselves and others.
| Hygiene Practices | Description |
|---|---|
| Handwashing | Regular and thorough handwashing |
| Skin Care | Keeping skin clean and dry |
| Clean Clothing | Wearing clean and breathable clothing |
Natural Antifungal Agents
*In Ayurveda, natural antifungal agents play a crucial role in combating fungal infections. These agents, derived from plants and herbs, have potent antifungal properties that can effectively target and eliminate fungal pathogens. A variety of natural antifungal agents are used in Ayurvedic treatments, including neem, turmeric, and garlic. These agents are known for their therapeutic effects and are often incorporated into topical ointments, oils, and oral remedies. Additionally, a balanced diet rich in antifungal foods can further enhance the body’s natural defense against fungal infections. Below is a table highlighting some common natural antifungal agents used in Ayurveda:
| Antifungal Agent | Source | Properties |
|---|---|---|
| Neem | Tree | Antimicrobial, Antifungal |
| Turmeric | Root | Anti-inflammatory, Antifungal |
| Garlic | Bulb | Antimicrobial, Antifungal |
- Incorporating these natural antifungal agents into daily routines can provide a holistic approach to preventing and treating fungal infections. It is important to note that while these agents are effective, consulting with an Ayurvedic practitioner is recommended for personalized treatment plans and dosage recommendations.
Environmental Factors
Environmental factors play a significant role in the development and spread of fungal infections. Moist and warm environments provide an ideal breeding ground for fungi. Additionally, poor ventilation and excessive humidity can contribute to the proliferation of fungal spores. It is important to be mindful of these environmental factors and take appropriate measures to create a clean and dry environment that is inhospitable to fungal growth. The table below highlights some common environmental factors that can influence fungal infections:
| Environmental Factor | Impact on Fungal Infections |
|---|---|
| Moisture and Humidity | Promotes fungal growth |
| Poor Ventilation | Encourages fungal spores |
| Warm and Damp Conditions | Ideal for fungal proliferation |
- Regularly clean and dry damp areas
- Ensure proper ventilation in living spaces
- Use natural antifungal agents to maintain a healthy environment
It is essential to address these environmental factors to prevent the onset and recurrence of fungal infections.
Conclusion
Efficacy of Ayurvedic Treatment
*Ayurvedic treatment has shown remarkable efficacy in combating fungal infections. The holistic approach of Ayurveda addresses the root cause of the infections, leading to long-term relief. Additionally, the use of herbal remedies and natural antifungal agents has proven to be highly effective. A comparative study of Ayurvedic treatment alongside modern medicine would provide valuable insights into its clinical benefits.
Ayurveda emphasizes the importance of balance in the body and mind, which is crucial for preventing and treating fungal infections. This ancient practice offers a promising avenue for the management of such conditions.
| Clinical Benefits | Holistic Approach | Herbal Remedies |
|---|---|---|
| Long-term relief | Address root cause | Effective |
Integration with Modern Medicine
Ayurvedic treatment for fungal infections can be integrated with modern medicine to provide a comprehensive approach to patient care. The combination of traditional Ayurvedic remedies and modern medical interventions can offer a holistic treatment plan that addresses the root cause of the infection. By incorporating herbal formulations and dietary recommendations from Ayurveda, patients can experience a more balanced and sustainable healing process. It is important to recognize the value of both systems and work towards a collaborative model of healthcare.
Integrating Ayurvedic and modern medical treatments can lead to improved patient outcomes and a more personalized approach to healthcare.
| Ayurvedic Treatment | Modern Medicine |
|---|---|
| Herbal Remedies | Antifungal Medications |
| Dietary Recommendations | Topical Treatments |
Future Research and Development
In conclusion, the integration of Ayurvedic treatment with modern medicine shows promise in addressing fungal infections. Further research and development are needed to explore the efficacy of Ayurvedic remedies and their potential side effects. A collaborative approach between traditional and modern medical practices can lead to more comprehensive and effective treatments. The table below outlines key areas for future investigation.
| Research Areas | Importance |
|---|---|
| Clinical trials | To evaluate the effectiveness of Ayurvedic remedies in real-world scenarios |
| Safety profiles | To assess the potential risks and adverse reactions of herbal treatments |
| Standardization | To establish consistent quality and dosage guidelines for herbal formulations |
- Continued exploration of natural antifungal agents and their mechanisms of action
- Emphasis on education and awareness regarding hygiene practices and their role in preventing fungal infections
The collaboration between traditional Ayurvedic knowledge and modern scientific research holds great potential for advancing the treatment and prevention of fungal infections.
Frequently Asked Questions
What are the common symptoms of fungal infections?
Common symptoms include itching, redness, swelling, and irritation of the affected area. In some cases, there may be skin peeling, rashes, or discomfort.
Can Ayurvedic remedies be used alongside conventional antifungal medications?
It’s important to consult with a healthcare professional before combining Ayurvedic remedies with conventional medications to ensure safety and effectiveness.
Are there any dietary restrictions for individuals with fungal infections?
Ayurveda recommends avoiding excessively sweet, sour, and oily foods, as well as fermented and processed items. A diet rich in fresh fruits, vegetables, and whole grains is beneficial.
What are some natural antifungal agents recommended in Ayurveda?
Ayurvedic remedies may include neem, turmeric, coconut oil, aloe vera, garlic, and tea tree oil, which are known for their antifungal properties.
Is Ayurvedic treatment effective for chronic or recurring fungal infections?
Ayurvedic treatment focuses on addressing the root cause of the infection and strengthening the body’s natural defenses, which can be beneficial for chronic or recurring fungal infections.
Can environmental factors contribute to the development of fungal infections?
Yes, environmental factors such as humidity, poor ventilation, and exposure to mold and fungi can create conditions conducive to fungal growth and infection.